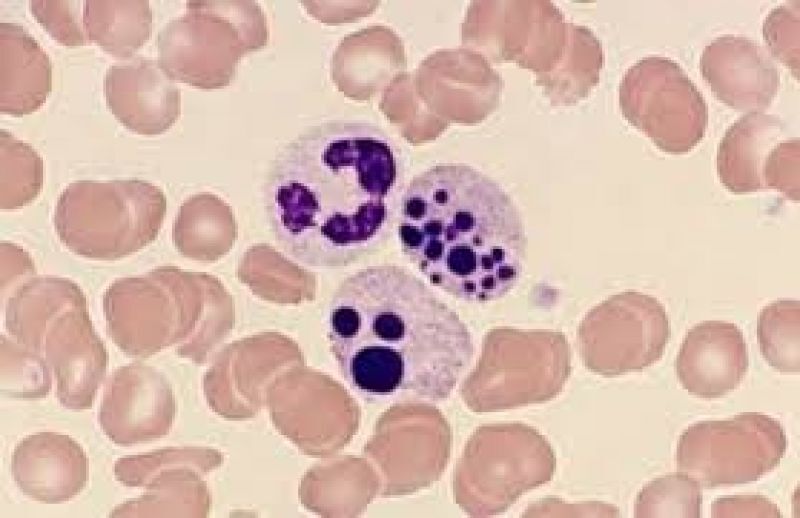

Qual é o conceito de apoptose?
É a morte celular programada.
Nessa condição, a célula está destinada a ser destruída, então ela ativa enzimas que irão degradar seu DNA, proteínas nucleares e citoplasmáticas.

A apoptose ocorre somente em condições patológicas?
Não, ela também ocorre de maneira fisioógica:
-Renovação epitelial/de hematopoiéticas.
-Involução cíclica de órgãos reprodutivos.
-Atrofia induzida por hormônios
-Regressão de tumores.
Por meio de qual mecanismo a célula entra em apoptose?
A apoptose ocorre necessariamente por meio da via das caspases.
Essa via pode ser ativada de maneira intrínseca ou extrínseca.
Nesse caso, a célula vai soltando corpos apoptóticos, que sào fragmentos encapsulados dessa própria célula, isso NÃO causa inflamação do tecido.
Corpos apoptóticos posteriormente são fagocitados pelos macrófagos.

No que consiste a via mitocondrial/intrínseca da apoptose?
É quando o sinal para que a célula se destrua vem da própria célula, de um de seus genes ou proteínas
Aqui, substância Bcl2, que estabiliza membrana mitocondrial é suprimida, e isso faz com que tenha-se liberação do citocromo C da matriz mitcondrial-> ativador das caspases
O citocromo C inibe as proteínas da família de proteínas IAC (inibidoras de apoptoses) = apoptose.
Os sinais apoptoticos ainda ativam sensores Bax e Bak = mais liberação de citocromo C.
Citocromo C é que ativa a via das caspases, fragmentando a célula.
No que consiste a via extrínseca / “receptor de morte”?
É quando a célula, doente/desnecessária, recebe um sinal de outras células para entrar em apoptose.
Molécula de outra célula se liga ao receptor dessa célula e induz uma apoptose
TNF e Fas = receptores que, quando alguma molécula se liga a eles, tem-se o início da via das caspases = apoptose.
Por exemplo, se o linfócito T, na medula do Timo, reagir às células próprias do indivíduo, é induzida a apoptose desse linfócito por expressão do Fas, que se liga no receptor morte = apoptose
Qual o processo oposto à apoptose?
Mitose
Equilíbrio mitose-apoptose define o tecido normal.
Apoptose insuficiênte pode ser patológico?
Sim.
É o equilíbrio mitose-apoptose define o tecido normal.
Se houver muito mais mitose que apoptose, tem-se o aumento da celularidade do tecido. Ex.:
-nas neoplasias;
-doenças autoimunes por falha de apoptose dos linfócitos T que atacam células do corpo;
- infecções como por HPV, que impedem a apoptose de células do epitélio, que tendem a se acumular.
Ou mesmo durante a atresia de esôfago, em que há apoptose insuficiente durante a organogênese!
Excesso de apoptose pode ser patológico?
Sim.
Ex.:
-Doenças neurodegenerativas.
Como fica o núcleo/citoplasma da céula em apoptose?
Picnótico.
Núcleo muito denso, cromatina condensada
Citoplasma reduzido = + espaço entre as células

Na via intrínseca, diante de um dano ao DNA, como agem os supressores tumorais e quais são estes ?
É o p53 e o Rb (retinoblastoma)
Ele vai agir interrompendo o ciclo celular e ativando diretamente as caspases efetoras
Qual a característica de uma agressão celular que conduz a necrose?
Se trata de uma agressão suficientemente forte, em que a célula se torna incapaz de se adaptar e caminha para a morte; se trata de um dano irreversível.
Qual é o conceito de necrose celular?
É a condição de morte celular secundária a ação de um agente agressor químico, físico, biológico, alteraçòes gnéticas ou imunológicas e sua resposta tecidual.
Nessa ocasião, há perda da homeostase da célula, enzimas lisossômicas são liberadas no citoplasma e digerem a célula.
A necrose ocasiona inflamação de teciduos adjacentes ? Por que?
Sim.
Pois a membrana é desintegrada e há liberação de conteúdo celular ao meio externo, conduzindo a inflamaçàodesse tecido
Qual é o momento definidor de que aquela célula entrará em necrose?
É quando a função mitocondrial é comprometida.
Quais são as principais agressòes que conduzem a necrose celular?
-Isquemia
-Substâncias tóxicas
-Infecções
-Traumas
Temperatura/radiação/choque
-Defeitos genéticos
Qual é o processo desde a agressão da célula até a sua necrose?
- Um estímulo letal leva à hipóxia
- Como a célula entra em hipóxia, a mitocôndria
falha, falta energia para a célula e, portanto, há
falência da bomba sódio e potássio - Como a bomba não funciona, grande quantidade
de sódio entra na célula, causando edema
intracelular e desestabilização das endomembranas - Essa desestabilização promove a liberação de
cálcio, que culmina com a ativação de fosfolipases,
proteases e outras enzimas, as quais destroem as
endomembranas - A hipóxia (etapa 1) também leva ao metabolismo
anaeróbio, o qual desencadeia o acúmulo de lactato,
que também ativa fosfolipases, proteases e outras
enzimas, as quais destroem as endomembranas
Na morte celular, as principais/mais visíveis alteraçòes são no citoplamsa, e não no núcleo.
Essa afirmaçào é correta?
Não!
Na morte celular, as alteraçòes mais prevalentes e visíveis se dão no NÚCLEO, poucas são visíveis no citoplasma.
A partir da exposição da célula ao agente agressor, quais são as etapas celulares até a necrose?
- Tumefação celular (Degeneração hidrópica)
- Picnose (nucleo fica pequeno/compacto)
- Cariorrexis (núcleo picnótico se fragmenta)
- Cariólise (os fragmentos do núcleo se dispersam no citoplasma)
- Necrose (os fragmentos nucleares desaparecem e tem-se só uma célula morta)

O que são fenômenos autolíticos da necrose?
liberação das enzimas da própria célula, como fosfolipases e lisozimas, que destroem as endomembranas. Nesses casos geralmente a arquitetura celular é preservada
O que são fenômenos heterolíticos da necrose?
Quando o conteúdo intracelular vaza, acontecem
os fenômenos heterolíticos (resposta do organismo): o sistema imunológico, por via vascular, promove uma reação contra aquela área.
Nesses casos geralmente há desorganização da
arquitetura celular
Quais as características da necrose coagulativa?
A estrutura básica das células necróticas é
mantida por um intervalo de alguns dias, depois os
restos celulares são removidos por fagocitose
Os tecidos afetados exibem uma consistência
firme e esbranquiçada e o órgão permanece
preservado
Nesse tipo de necrose há predomínio dos
fenômenos autolíticos e ocorre desnaturação e coagulação das
proteínas estruturais e enzimas
As necroses de coagulação, na sua grande maioria,
são observadas nos infartos
Como é a macroscopia de um órgão que entrou em necrose coagulativa?
A área morta tem cor amarelo-pálida, sem brilho, textura firme, de limites mais ou menos precisos e de forma irregular ou triangular, dependendo do órgão atingido e do tipo de circulação que esse
órgão apresenta

Como é a microscopia de um órgão em necrose coagulativa?
A célula mantém sua arquitetura, mas fica sem
núcleo e com citoplasma eosinofílico (rosa).
Portanto, a área necrótica é caracterizada pela
conversão da célula em arcabouço acidofílico
opaco (“células em lápide”)

O que é a necrose hemorrágica e quais suas características?
- É um tipo de necrose coagulativa
- O dano ao tecido impede que o sangue venoso
saia do órgão, levando à hemorragia - Este evento interrompe a oxigenação adequada do
tecido, causando ainda mais necrose - Ocorre em órgãos que possuem duas ou mais
fontes de suprimento de sangue, como o fígado,
pulmão e baço
-Iisquemia de um vaso = necrose coagulativa, mas a outra circulação ainda deposita sangue no tecido necrosado = necrose hemorrágica; por isso que a característica do pulmão é necrose hemorrágica.
Torção testicular conduz a necrose hemorrágica pois há rotura da veia testicular enquando a artéria testicular se mantém intacta = hipóxia “congestiva” desse tecido = necrose coagulativa com sangue chegando pela arterai e sem conseguir sair = necrose hemorrágica


















